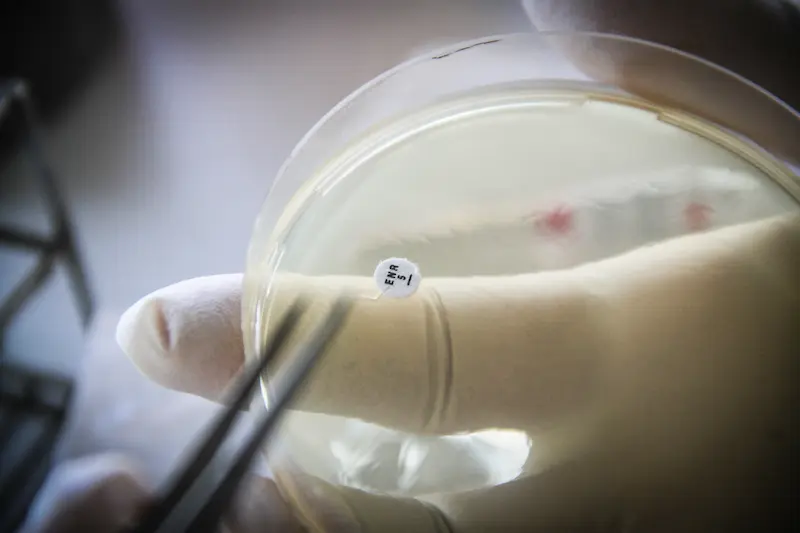

Mikro TESE (TESA-TESE) Nedir, Nasıl Yapılır?
- Yumurta Donasyonu
- Sperm Donasyonu
- Embriyo Donasyonu
- Mikro TESE (TESA -TESE)
- Tüp bebek
- PGT – Preimplantasyon Genetik Tanı
- Azospermi
- Mikroenjeksiyon
- IMSI
- Serum Tedavisi
- Tandem Tedavisi
- Microsort Yöntemi
- Sperm Chip (Fertile Plus)
- Ovulasyon İndüksiyonu
- Vajina Estetiği (Labioplasti)
- Kızlık Zarı Dikimi
- “Dondurma” İşlemleri

MİKRO-TESE KİMLERE ÖNERİLİR?
Menide canlı sperm hücresine rastlanmadığı (azospermi) durumlarda, baba olma yolundaki engelleri aşmak adına Mikro-TESE en etkili yöntemdir. Özellikle hormonal dengesizlikler, genetik faktörler veya kanal tıkanıklıkları nedeniyle doğal yolla sperm çıkışı gerçekleşmeyen erkeklerde, doğrudan testis dokusundan sağlıklı hücre elde edilmesini hedefler.
YAPILAN TEST VE TETKİKLER
En doğru cerrahi planı belirlemek amacıyla süreç kapsamlı kontrollerle başlar. Erkek hastalarımız için detaylı hormon profili analizi ve genetik taramalar gerçekleştirilir; testis yapısının değerlendirilmesi amacıyla skrotal doppler ultrason tetkikleri yapılarak operasyon süreci titizlikle yapılandırılır.
TEDAVİ YATIRIMI VE DETAYLAR
Ivox Tüp Bebek Merkezi bünyesinde uygulanan Mikro-TESE operasyon ücretini öğrenmek için bizimle iletişime geçebilirsiniz.
Bilgilendirme: Operasyon maliyetine ek olarak; anestezi türü, doku dondurma işlemleri veya genetik incelemeler gibi yan hizmetler hakkında size özel planlama için ekibimizle iletişime geçebilirsiniz.
BAŞARI ORANLARIMIZ
Mikro-TESE başarısı; doku yapısı, genetik zemin ve uzman tecrübesine bağlı olarak değişmektedir. Merkezimizin teknik donanımı ve deneyimli kadrosu, en zorlu vakalarda bile sperm elde etme şansını dünya standartlarında tutmaktadır.
Kişiselleştirilmiş Cerrahi ile Sperm Bulma Şansı:
%60-%70'e Varan Başarı
Mikro TESE
Mikro TESE, sperm üretimi olmayan veya azalmış erkeklerde testisten mikroskobik yöntemlerle sperm elde edilmesini sağlayan cerrahi işlemdir. Ivox Tüp Bebek Merkezi, Kıbrıs’ta bu alanda uzmanlaşmış üroloji ve embriyoloji ekibiyle Mikro TESE işlemini güvenli ve yüksek başarı oranlarıyla uygulamaktadır.
O zaman öğrenelim: Azospermi Nedir, Tedavisi Var mı?
Mikro TESE Nedir?

Mikro TESE, sperm üretiminin testiste yetersiz veya odaksal olarak sınırlı olduğu erkeklerde, mikroskop yardımıyla sperm arama ve çıkarma işlemidir. Bu yöntem, özellikle non-obstrüktif azospermi (NOA) tanısı konmuş erkeklerde uygulanır.
Geleneksel TESE yöntemlerinden farklı olarak Mikro TESE’de, ameliyat mikroskobu (genellikle ×20–25 büyütme kapasitesine sahip) kullanılarak, testis dokusu detaylı bir şekilde incelenir. Amaç; sperm üretimi yapan seminifer tübülleri ayırt edip, en verimli dokudan örnek alarak canlı sperm elde etmektir.
Mikro TESE, doğrudan üretken tübülleri hedeflediği için hem sperm bulma oranını artırır (%50-65) hem de testise verilen zararı en aza indirir.
Mikrocerrahi TESE İşlemi Neyi Hedefler?
Mikro TESE’nin birincil amacı, canlı sperm hücresini doğrudan testisten izole etmek ve laboratuvarda ICSI (mikroenjeksiyon) için kullanılabilir hale getirmektir.
İşlem, sperm kanalında tıkanıklık olmayan ama yine de menide sperm bulunmayan erkeklerde uygulanır. Mikroskobik düzeyde seçici dokular alınarak hem verim hem de doku bütünlüğü korunur.
Her testiste milyonlarca seminifer tübül bulunur ancak sperm sadece birkaç odakta üretilebilir. Bu fark, yalnızca mikroskop altında görülebilir.
Hangi Durumlarda Klasik TESE Yeterli Olmaz?
Klasik TESE, cerrahi olarak testisten rastgele alınan doku parçalarıyla uygulanır. Ancak bu yaklaşımda:
Üretim olmayan alanlardan doku alınma riski yüksektir
Geniş doku çıkarımı testis fonksiyonlarını olumsuz etkileyebilir
Sperm bulma ihtimali düşüktür (%30-40)
Mikro TESE ise, doku içinde spermatogenez varlığını doğrudan mikroskopla tespit eder. Bu da cerrahın yalnızca verimli tübüllere odaklanmasını sağlar.
Özellikle FSH yüksek, testis hacmi küçük hastalarda mikrocerrahi olmazsa olmazdır.
Ayrıca Mikro TESE:
Sklerotik, yani hasar görmüş dokularla üretken bölgeleri ayırt edebilir
Daha önce TESE yapılmış ve başarısız olmuş hastalarda bile sperm bulma şansı sunar
Genetik azospermi durumlarında bile canlı sperm yakalama potansiyeli taşır
TESA, TESE ve Mikro TESE Arasındaki Fark Nedir?

TESA, TESE ve Mikro TESE, testisten sperm elde etmeyi amaçlayan üç farklı cerrahi yöntemdir. Her biri farklı hasta profiline ve sperm üretim düzeyine göre uygulanır. Seçilecek yöntem, hem hastanın tanısına hem de testis dokusunun biyolojik yapısına göre belirlenir.
Mikro TESE Hangi Teknik Farkları İçerir?
| Yöntem | Açılımı | Uygulama Şekli | Görsellik | Sperm Bulma Başarısı |
|---|---|---|---|---|
| TESA | Testicular Sperm Aspiration | İğneyle testisten doku emilir | Körleme | %20-30 |
| TESE | Testicular Sperm Extraction | Cerrahi kesiyle doku alınır | Körleme | %30-40 |
| Mikro TESE | Mikroskopik TESE | Mikroskopla hedefli doku çıkarımı | Mikroskobik | %50-65 |
TESA, lokal anestezi altında uygulanan, en az invaziv yöntemdir. Ancak sperm üretimi çok az olan vakalarda yetersiz kalabilir.
TESE, cerrahi kesiyle yapılan daha geniş doku alımı sağlar fakat yine rastgele alınan dokularla çalışılır.
Mikro TESE ise yüksek çözünürlüklü cerrahi mikroskopla sadece aktif spermatogenez görülen tübülleri hedef alır. Böylece hem başarı oranı artar hem de testis hasarı en aza iner.
Mikro TESE, özellikle non-obstrüktif azospermi gibi zor vakalarda altın standarttır.
Hangi Yöntem Hangi Hasta Grubuna Uygulanır?
TESA → Obstrüktif azospermi (kanal tıkanıklığı var, üretim normal)
TESE → Karma vakalar (hafif üretim sorunu veya üretken alanlar var)
Mikro TESE → Non-obstrüktif azospermi (ciddi üretim bozukluğu)
Obstrüktif azospermi hastalarında basit yöntemler yeterli olurken, üretim problemi olan hastalarda mikrocerrahi şarttır.
Ek Farklılıklar Nelerdir?
Doku Hasarı: Mikro TESE ile doku kaybı en az seviyededir. TESE’de doku kaybı riski yüksektir.
Anestezi: TESA lokal, TESE ve Mikro TESE genellikle genel anestezi ile yapılır.
İyileşme Süresi: Mikro TESE sonrası iyileşme daha kontrollüdür çünkü daha az doku çıkarılır.
Laboratuvar Uyumu: Mikro TESE, ICSI (mikroenjeksiyon) için ideal kalitede sperm sunar.
Neden Mikro TESE Daha Çok Tercih Edilir?
Yüksek sperm bulma oranı
Daha az doku hasarı
Yeniden cerrahi yapılabilme imkânı
Daha az hormonal bozulma
Ivox Tüp Bebek Merkezi, Mikro TESE yöntemini yalnızca mikroskop eşliğinde, akademik eğitim almış androloji cerrahlarıyla uygular. Bu, işlemin kalitesini belirleyen en kritik faktördür.
Mikro TESE Kimlere Uygulanır?
Mikro TESE, ejakülatta sperm bulunmayan, özellikle non-obstrüktif azospermi (NOA) tanısı almış erkeklerde uygulanır. Bu grup hastalarda, sperm üretimi yok denecek kadar azdır veya yalnızca mikroskobik düzeyde bazı bölgelere sınırlıdır.
Mikro TESE Hangi Tanılar Sonrası Tercih Edilir?
Mikro TESE, aşağıdaki klinik durumlar sonrası tercih edilen ana sperm elde etme yöntemidir:
Non-obstrüktif azospermi (NOA): Sperm üretimi testiste odaksaldır.
Testis yetmezliği: Primer veya sekonder testiküler fonksiyon kaybı.
Klinefelter sendromu: XXY kromozom yapısına sahip erkeklerde üretim sınırlıdır.
Y kromozom mikrodelesyonları: Özellikle AZFc bölgesi silinmiş erkeklerde.
Kemoterapi veya radyoterapi sonrası: Spermatogenez zarar görmüş erkeklerde.
İnmemiş testis hikayesi olanlar: Geç inen testis üretimi olumsuz etkileyebilir.
İnfertilite öyküsü olan ve menide hiç sperm çıkmayan erkekler.
Ivox Tüp Bebek Merkezi’nde her hastaya özel genetik, hormonal ve ürolojik değerlendirme yapılmadan Mikro TESE önerilmez.
Genetik Faktörler Tedavi Kararını Nasıl Etkiler?
Genetik anomaliler, azospermi nedenlerinin %15-30’undan sorumludur. Mikro TESE öncesi hastalara genetik tarama (Y kromozom delesyonları ve karyotip analizi) yapılmalıdır.
AZFc delesyonu: Mikro TESE ile sperm elde etme şansı vardır (%50’ye kadar)
AZFa veya AZFb delesyonu: Sperm bulma olasılığı çok düşüktür (%0’a yakın)
Klinefelter vakaları: Genç yaşta yapılırsa sperm elde edilme şansı artar.
Genetik tanı, hem tedavi başarısını hem de doğacak çocuklarda olası genetik geçiş risklerini öngörmek için gereklidir.
Mikro TESE Her Azospermi Hastasına Uygulanır mı?
Hayır. Mikro TESE, yalnızca sperm üretiminin çok düşük olduğu ama tamamen kaybolmadığı hastalara önerilir. Şu durumlarda uygulanmaz:
Sertoli Cell Only Sendromu (tüm tübüller sperm üretmeyen yapıda ise)
Testislerde fibrozis (doku tamamen hasarlanmışsa)
Komple AZFa veya AZFb delesyonu (üretim genetik olarak mümkün değilse)
Bu hastalarda TESE veya TESA ile de sperm bulunma ihtimali yoktur ve alternatif yöntemler (donör sperm vb.) değerlendirilmelidir.
Hasta Değerlendirmesinde Hangi Parametreler Analiz Edilir?
Mikro TESE kararı öncesi, aşağıdaki kriterler detaylı olarak analiz edilir:
| Parametre | Açıklama |
|---|---|
| FSH seviyesi | Yüksekse sperm üretimi düşüktür |
| Testis hacmi | Küçük testis üretimin azaldığını gösterir |
| LH ve Testosteron | Hormonal denge değerlendirilir |
| Genetik testler | Kromozomal yapı ve delesyonlar tespit edilir |
| Önceki TESE deneyimi | Daha önce sperm bulunup bulunmadığı değerlendirilir |
Tüm bu değerlendirmeler, mikro TESE başarısını doğrudan etkiler.
Mikro TESE Nasıl Yapılır?
Mikro TESE işlemi, mikroskop yardımıyla testis dokusu içinde sperm üreten tübüllerin belirlenip, o bölgeden doku alınmasıyla yapılan bir mikrocerrahi operasyondur. İşlem, genellikle genel anestezi altında ve steril ameliyathane koşullarında gerçekleştirilir.
Amaç, sadece sperm üreten bölgelerden örnek alarak, hem sperm bulma şansını artırmak hem de testis hasarını minimumda tutmaktır.
İşlem Aşamaları Nelerdir?
Mikro TESE süreci aşağıdaki adımlar doğrultusunda yürütülür:
Hasta hazırlığı:
Hormon testleri, genetik analizler ve ultrason değerlendirmesi yapılır. İşlem günü hastaya anestezi uygulanır.Cerrahi kesi:
Skrotum (testis torbası) üzerinden küçük bir kesi açılır ve testis dışarı alınır.Testis dokusunun açılması:
Testis kapsülü (tunica albuginea) mikroskop altında dikkatlice kesilir.Mikroskobik inceleme:
Cerrahi mikroskopla seminifer tübüller 20–25 kat büyütülerek incelenir. Sperm üretimi olan tübüller ayırt edilir.Doku örneklemesi:
Yalnızca üretken görünen tübüller çok küçük parçalar halinde çıkarılır.Laboratuvara transfer:
Doku anında embriyologlara iletilir ve mikroskop altında sperm aranır.Sperm varsa:
Taze kullanım için ayrılır veya -196°C’de dondurularak saklanır.Kapanış:
Testis kapsülü ve cilt katları estetik dikişlerle kapatılır. Hasta uyanma odasına alınır.
Cerrahi Mikroskop Ne İşe Yarar?
Cerrahi mikroskop, testis içindeki tübüller arasında renk, kalınlık ve dolgunluk farklarını görmeyi sağlar. Bu farklar, hangi bölgelerde sperm üretildiğini gösterir.
Üretken tübüller: Genellikle daha opak, dolgun ve kıvrımlıdır.
Üretken olmayan tübüller: İnce, şeffaf ve düz yapıdadır.
Mikroskop olmadan bu farklar ayırt edilemez. Bu nedenle klasik TESE’de sperm bulamayan hastalarda mikro TESE ile başarı elde edilir.
İşlem Ne Kadar Sürer?
Mikro TESE işlemi ortalama 1,5 – 3 saat arası sürer.
Operasyonun süresi, testisin yapısı ve sperm arama sürecine göre değişebilir.
Aynı seansta her iki testis de incelenebilir.
Ivox Tüp Bebek Merkezi’nde işlem süresince, ürolog ve embriyolog eş zamanlı çalışarak anlık karar verir.
İşlemden Sonra Sperm Bulunamazsa Ne Olur?
Sperm bulunamaması durumunda doku, ileri düzey laboratuvar teknikleriyle tekrar analiz edilir. Yine sonuç negatifse:
Donör sperm seçeneği gündeme gelir
Sperm üretimini uyarmaya yönelik hormon tedavileri önerilebilir
Klinik, sonraki tedavi planını hasta ile birlikte oluşturur
Mikro TESE İşlem Süresi ve İyileşme Süreci Nasıldır?
Mikro TESE işlemi, ortalama 90 ila 180 dakika arasında sürer. Süre, testis dokusundaki sperm bulma zorluğuna ve her iki testisin işlem görüp görmemesine göre değişir.
İşlem genellikle aynı gün taburcu edilerek tamamlanır. Hasta, birkaç saat gözlem altında tutulduktan sonra evine gönderilir. Dikişler genellikle kendiliğinden eriyen yapıdadır.
Operasyon süresi uzun gibi görünse de, mikroskop altında yapılan detaylı tarama bu zaman aralığını gerektirir.
Mikro TESE Sonrası İyileşme Süreci Nasıldır?
İyileşme süreci kişiden kişiye değişmekle birlikte genellikle hafif ve hızlı seyreder. Ortalama 3 ila 5 gün içinde hasta günlük yaşamına dönebilir.
İyileşme sürecinde dikkat edilmesi gerekenler:
1 hafta boyunca cinsel ilişki önerilmez
3-5 gün ağır fiziksel aktiviteden kaçınılmalıdır
Sıcak banyo ve sauna gibi aktiviteler 10 gün süreyle sınırlandırılır
Antibiyotik ve ağrı kesiciler reçeteye uygun kullanılmalıdır
Ağrı ve Şişlik Normal midir?
Evet. İşlem sonrası hafif ağrı, morarma ve skrotumda şişlik normaldir. Bu etkiler genellikle ilk 48 saat içinde en yoğun haldedir ve ardından hızla azalır.
| Belirti | Süre | Müdahale |
|---|---|---|
| Ağrı | 2–3 gün | Oral analjeziklerle kontrol altına alınır |
| Morarma | 4–5 gün | Genellikle müdahale gerektirmez |
| Şişlik | 3–7 gün | Soğuk kompres önerilir |
Ani artan ağrı, ateş veya akıntı görülürse mutlaka hekime başvurulmalıdır.
Dikişler Ne Zaman Düşer?
Dikişler genellikle kendiliğinden eriyen türdedir ve 7–10 gün içinde cilt yüzeyinden kaybolur. Özel bir pansuman gerekmez. Hastaya işlem sonrası detaylı bakım talimatları yazılı ve sözlü olarak verilir.
İşlemden Sonra İşe Dönüş Ne Kadar Sürer?
Masa başı çalışanlar için: 2–3 gün içinde işe dönüş mümkündür
Fiziksel efor gerektiren işlerde: En az 5–7 gün dinlenme önerilir
Mikro TESE sonrası iyileşme süreci, klasik TESE’ye göre daha hızlı ve konforludur çünkü doku hasarı minimum düzeydedir.
Mikro TESE Başarı Oranı Nedir?

Mikro TESE ile sperm bulma oranı, hastanın klinik durumuna bağlı olarak %30 ile %65 arasında değişir. En yüksek başarı, testis dokusunda odaksal sperm üretimi olan non-obstrüktif azospermi hastalarında elde edilir.
Ivox Tüp Bebek Merkezi’nde, ileri mikroskop teknolojisi ve multidisipliner yaklaşım sayesinde başarı oranları dünya ortalamasına eşdeğerdir.
Sperm Bulma Oranı Hangi Faktörlere Bağlıdır?
Mikro TESE’de başarıyı etkileyen başlıca parametreler:
| Faktör | Açıklama |
|---|---|
| Genetik yapı | AZFc delesyonu varsa başarı %50’ye kadar çıkar |
| FSH seviyesi | Yüksek FSH genellikle düşük üretime işaret eder |
| Testis hacmi | Küçük testis, düşük sperm üretimiyle ilişkilidir |
| Önceki TESE deneyimi | Başarısızlık öyküsü olanlarda oran azalabilir |
| Hastanın yaşı | Genç yaşta yapılan uygulamalarda başarı daha yüksektir |
Örneğin: AZFc bölgesel delesyon olan genç bir erkekte başarı %60’a kadar çıkabilirken, AZFa delesyonu olan bir erkekte sperm bulma şansı yok denecek kadar düşüktür.
Hasta Gruplarına Göre Ortalama Başarı Yüzdeleri
| Hasta Grubu | Ortalama Sperm Bulma Oranı (%) |
|---|---|
| Non-obstrüktif azospermi (NOA) | %50 – %65 |
| Obstrüktif azospermi (TESA sonrası başarısız olan) | %30 – %45 |
| Klinefelter Sendromu | %25 – %40 |
| AZFc delesyonu olanlar | %50’ye kadar |
| Önceki başarısız TESE öyküsü olanlar | %20 – %30 |
Ivox Tüp Bebek Merkezi, genetik risk taşıyan hastalarda kişiselleştirilmiş tedavi algoritmaları uygular. Böylece uygun hastada doğru zamanda yapılan müdahale başarıyı artırır.
Mikro TESE ile Sperm Bulunamazsa Ne Olur?
Eğer işlem sırasında sperm bulunamazsa:
Doku ileri analiz için özel laboratuvar işlemlerine alınır
Genetik tekrar değerlendirilir
Alternatif tedavi seçenekleri (donör sperm, embriyo donasyonu) gündeme gelir
Hormonal tedavi ile ikinci girişim planlanabilir
Mikro TESE’de elde edilen sperm hemen kullanılabileceği gibi dondurularak da saklanabilir. Dondurulmuş spermle ICSI’de döllenme oranı taze sperm kadar yüksektir.
Mikro TESE ile Elde Edilen Spermler Nasıl Kullanılır?
Mikro TESE ile testisten elde edilen canlı spermler, doğrudan ICSI (Intracytoplasmic Sperm Injection) yöntemiyle yumurtaya enjekte edilerek kullanılır. Bu süreç klasik tüp bebek (IVF) protokolünün özel bir uygulamasıdır.
Mikro TESE’nin amacı sadece sperm bulmak değil, aynı zamanda bu spermleri sağlıklı embriyolara dönüştürebilecek kalitede elde etmektir.
Mikro TESE ile Elde Edilen Spermler Hemen mi Kullanılır?
Evet. Eğer aynı siklus içinde eşten yumurta toplama işlemi de planlandıysa, taze sperm doğrudan kullanılabilir. Ancak şu durumlarda spermler dondurularak (kriyoprezervasyon) saklanır:
Eşin yumurta toplama günü farklı bir zamana planlandıysa
Aynı gün sperm bulunmasına rağmen döllenme planlanmıyorsa
İleriye dönük tedavi denemeleri için sperm saklanmak isteniyorsa
Sperm dondurma işlemi, Ivox Tüp Bebek Merkezi laboratuvarlarında -196°C sıvı azot tanklarında güvenle yapılır.
Mikro TESE Spermleriyle ICSI Süreci Nasıl İşler?
Sperm seçimi: Embriyologlar, Mikro TESE dokusundan elde edilen canlı, hareketli veya kuyruk yapısı sağlam spermleri seçer.
Yumurta toplama: Kadının hormon tedavisi sonrası yumurtaları toplanır.
Mikroenjeksiyon: Her yumurtaya özel mikro iğneyle tek bir sperm enjekte edilir.
Döllenme ve kültür: Oluşan embriyolar laboratuvar ortamında 3-5 gün izlenir.
Transfer: En kaliteli embriyo rahme yerleştirilir.
Bu yöntemle, testiste canlı sperm bulunduğu sürece, menide hiç sperm olmasa dahi çiftin genetik çocuğu olabilir.
Taze ve Dondurulmuş Sperm Arasında Fark Var mı?
Hayır. Yapılan klinik çalışmalara göre, dondurulmuş Mikro TESE spermleriyle yapılan ICSI uygulamalarında döllenme, embriyo kalitesi ve gebelik oranları, taze spermle elde edilen sonuçlara çok yakındır.
| Kriter | Taze Mikro TESE Sperm | Dondurulmuş Mikro TESE Sperm |
|---|---|---|
| Döllenme oranı | %65–75 | %60–70 |
| Embriyo kalitesi | Yüksek | Yüksek |
| Gebelik oranı | %40–55 | %35–50 |
Ivox Tüp Bebek Merkezi, dondurulmuş spermlerin çözülme sonrası canlılığını artırmak için ileri seviye kriyoprotektan ve çözme teknikleri kullanır.
Mikro TESE Fiyatları Ne Kadar?
Mikro TESE fiyatları, hastanın klinik durumuna, laboratuvar ihtiyaçlarına ve ek tedavi prosedürlerine göre değişiklik gösterir. Mikro TESE işlemi, 2025 yılı itibarıyla ortalama 1.800 – 3.500 € aralığında ücretlendirilir.
Net fiyatlandırma için hastanın detaylı değerlendirilmesi ve tedavi planlaması gereklidir.
Mikro TESE Maliyetini Etkileyen Faktörler Nelerdir?
| Etken | Açıklama |
|---|---|
| Anestezi türü | Lokal mi, genel mi kullanılacağı fiyatı etkiler |
| İşlem tekrarı | Önceki başarısız denemeler varsa süre uzar |
| İki testis çalışması | Her iki testisin incelenmesi maliyeti artırabilir |
| Sperm dondurma | Kriyoprezervasyon ek ücret gerektirir |
| Tüp bebek tedavisine entegrasyon | Mikro TESE + ICSI kombinasyonu paket fiyatı değiştirir |
Bazı merkezler işlem sonrası sperm saklama ve ICSI hizmetlerini paket halinde sunarken, bazıları ayrı ücretlendirir.
Mikro TESE SGK veya Özel Sağlık Sigortası Kapsamına Girer mi?
Kıbrıs’ta özel tüp bebek merkezlerinde yapılan işlemler, Türkiye Cumhuriyeti Sosyal Güvenlik Kurumu (SGK) tarafından karşılanmaz. Ancak bazı uluslararası özel sağlık sigortaları, Mikro TESE’nin cerrahi kısmını karşılayabilmektedir. Bu durum, hastanın poliçe kapsamına göre değişiklik gösterir.
'da yayınlandı KHALIDA ALIEVATrustindex, incelemenin orijinal kaynağının Google olduğunu doğrular. Это место Надежды для семейных пар 🙏🙏 Тут работают отличные специалисты и дарят людям счастье💞❤️'da yayınlandı Yavuz selim KibarTrustindex, incelemenin orijinal kaynağının Google olduğunu doğrular. Mükemmel hizmet, memnun kalmayana denk gelmedim'da yayınlandı umut batırTrustindex, incelemenin orijinal kaynağının Google olduğunu doğrular. Bizi, çok iyi karşıladılar vallahi memnun kaldık hiçbir sorun çıkmadı şükür.'da yayınlandı Taha KalTrustindex, incelemenin orijinal kaynağının Google olduğunu doğrular. Geldiğimde geçmiş çocukları görmek bile çok tatlıydı'da yayınlandı Nazmi Selman KalTrustindex, incelemenin orijinal kaynağının Google olduğunu doğrular. Yenilikçi bakış açısı ve yüksek hizmet kalitesine sahip üst düzey bir klinik. Hasta merkezli yaklaşıma ve memnuniyet öncelikli hizmet anlayışına sahiplerdir.
Mikro TESE ile ilgili Sıkça Sorulan Sorular
Mikro TESE sonrası iyileşme süreci ne kadar sürer?
Mikro TESE sonrası çoğu hastada iyileşme süreci 7-10 gün içinde tamamlanır. İlk birkaç gün hafif ağrı ve şişlik normaldir. Tam fiziksel aktivitelere dönüş için doktorun önerdiği süre beklenmelidir.
TESA işlemi sonrası sperm hemen kullanılabilir mi?
Evet, TESA işlemi sonrası elde edilen spermler taze olarak kullanılabilir veya dondurularak ilerleyen dönemlerde tüp bebek tedavisinde kullanılmak üzere saklanabilir.
Mikro TESE veya TESA işlemleri cinsel performansı etkiler mi?
Genellikle hayır. Mikro TESE veya TESA işlemleri testislerde küçük müdahalelerle gerçekleştirilir ve cinsel performans üzerinde kalıcı bir olumsuz etki bırakmaz.
Mikro TESE ile alınan spermler kaç yıl saklanabilir?
Dondurulan spermler, uygun saklama koşullarında yıllarca (genellikle 10 yıldan fazla) bozulmadan korunabilir. Saklama süresi merkez politikalarına ve ülke mevzuatına göre değişebilir.
Azospermi kesin kısırlık anlamına mı gelir?
Hayır. Azospermi, ejakülatta sperm olmaması anlamına gelir ancak bu durum her zaman kalıcı kısırlık anlamına gelmez. Mikro TESE veya TESA gibi yöntemlerle sperm bulunarak çocuk sahibi olma şansı elde edilebilir.
Detaylı bilgi almak için iletişime geçin.
Bize yazmaktan çekinmeyin.
Telefon
+90 (533) 823 44 94
info@ivoxtupbebekmerkezi.com
Adres
Kazım Nami Duru Sk No 6, Kıbrıs / Lefkoşa 99010